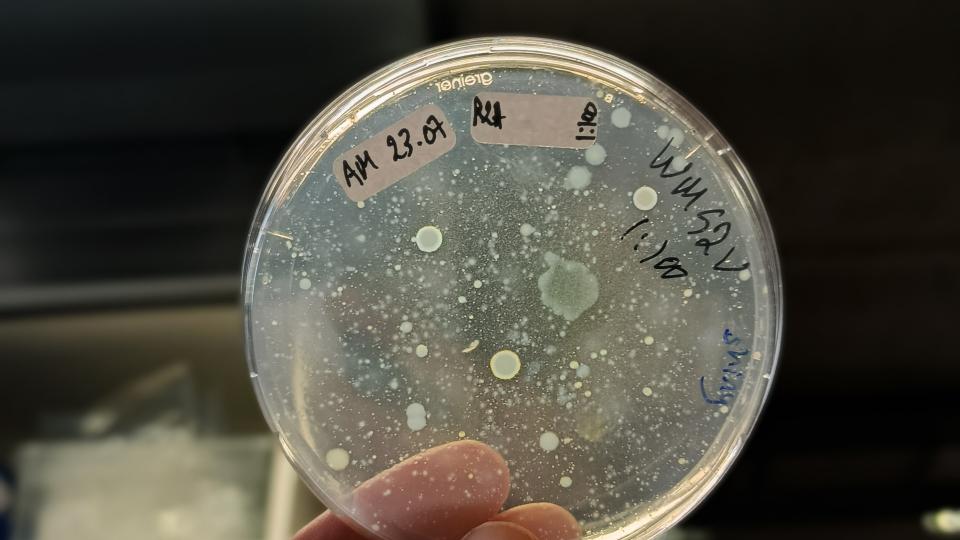
Figure 2: Microbial colonies cultured from Stuckenia pectinata's tissue (Mahdjoub, 2025), ALT: Petridish with growing microbial colonies of different shapes and sizes.

PlantsCoChallenge
Projektsteckbrief
Laufzeit

Unterwasserpflanzen sind Schlüsselkomponenten in aquatischen Ökosystemen, sie bieten wichtige Dienstleistungen wie Primärproduktion, Nährstoffzyklus, Sauerstoffzufuhr und Habitat. Diese Ökosystem-Denstleistungen aufrechtzuerhalten ist ausschlaggebend für den Schutz von Biodiversität und Anpassungen an den Klimawandel. Die Vorkommen an Unterwasserpflanzen gehen jedoch weltweit zurück. Zu untersuchen, wie Unterwasserpflanzen sich gegenüber Stressfaktoren in Seen verhalten, insbesondere bei Erwärmung und Sauerstoffmangel, ist daher wichtig, auch da die Interaktionen dieser Stressoren bisher zu wenig untersucht sind. Ein ganzheitlicher Ansatz, der physiologische und morphologische Antworten sowie die Rolle des Mikrobioms einbezieht, könnte neue Einblicke zur Frage der -Resilienz von Unterwasserpflanzen gegenüber multiplen Stressoren bringen. Biotische Stressfaktoren wie Pathogene, sind für terrestrische Pflanzen zudem weit mehr untersucht als für Süßwasserpflanzen, könnten aber sowohl zum Stress als auch Stress-Resilienz beitragen, auch durch Interaktionen mit anderen Stressoren.
In der DFG-ForschungsgruppeProjekt “PlantsCoChallenge”, geleitet durch Prof. Dr. Eva Stukenbrock vom Kiel Plant Centre, werden physiologische Anpassungen von Pflanzen an abiotische sowie biotische Stressfaktoren untersucht. Dabei werden unterschiedliche Organisationsstufen einbezogen: von subzellulären physiologischen Markern, Transkriptom, Stoffwechselprodukten bis zu morphologischen Eigenschaften und Interaktionen mit Endophyten. Es werden dafür 5 Pflanzenarten untersucht, drei terrestrische Arten (Quinoa, Gerste, Meersenf) und zwei aquatische (Seegras, Kammlaichkraut).
Am IGB wird vor allem auf das Kammlaichkraut (Stuckenia pectinata) fokussiert, eine weltweit verbreitete Unterwasserpflanze, die tolerant gegenüber trüben, eutrophen Bedingungen sowie erhöhtem Salzgehalt ist und auch in Brackwasser vorkommt. Mit Hilfe von Labor- und Freilandexperimenten werden die physiologischen, morphologischen und Mikrobiom-Anpassungen gegenüber abiotischen (Erwärmung, Sauerstoffmangel) und biotischen (potentielle Pathogene) Stressfaktoren untersuchen. Es wird ein gemeinsames Experiment mit S, pectinata und Zostera marina durchgeführt, einer Seegrasart, die in der Gruppe von Prof. Dr. Thorsten Reusch vom GEOMAR Kiel untersucht wird. Das Microbiome wird gemeinsam mit der Gruppe von Prof. Dr. Eric Kemen der Universität Tübingen untersucht.

Kiel Plant Center - https://www.plant-center.uni-kiel.de/en
GEOMAR - https://www.geomar.de/
Zentrum für Molekularbiologie der Pflanzen (ZMBP) - https://uni-tuebingen.de/fakultaeten/mathematisch-naturwissenschaftliche-fakultaet/fachbereiche/zentren/zentrum-fuer-molekularbiologie-der-pflanzen/zmbp/
Universität Münster - https://www.uni-muenster.de/
DFG - Deutsche Forschungsgemeinschaft
https://www.dfg.de





